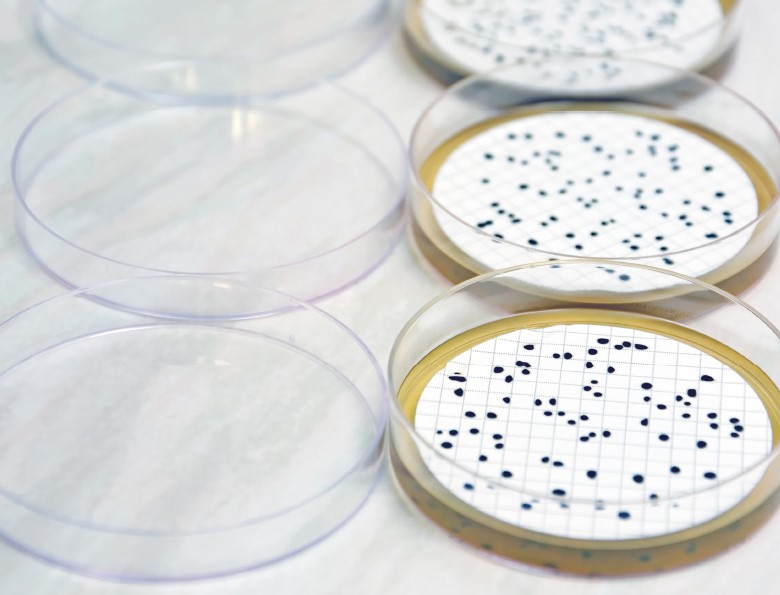

Hledání vhodných molekulárních markerů pro rozlišení různých druhů enterokoků
Enterokoky patří spolu se zástupci druhu Escherichia coli mezi tzv. indikátory fekálního znečištění, které se používají při hodnocení mikrobiologické kvality koupacích vod. Jejich stanovení se řídí vyhláškou MZ ČR č. 238/2011 Sb. a provádí se kultivačně na selektivních agarových médiích. Je známo, že ne všechny druhy enterokoků jsou fekálního původu a mají tedy přímou souvislost s fekálním znečištěním vody.